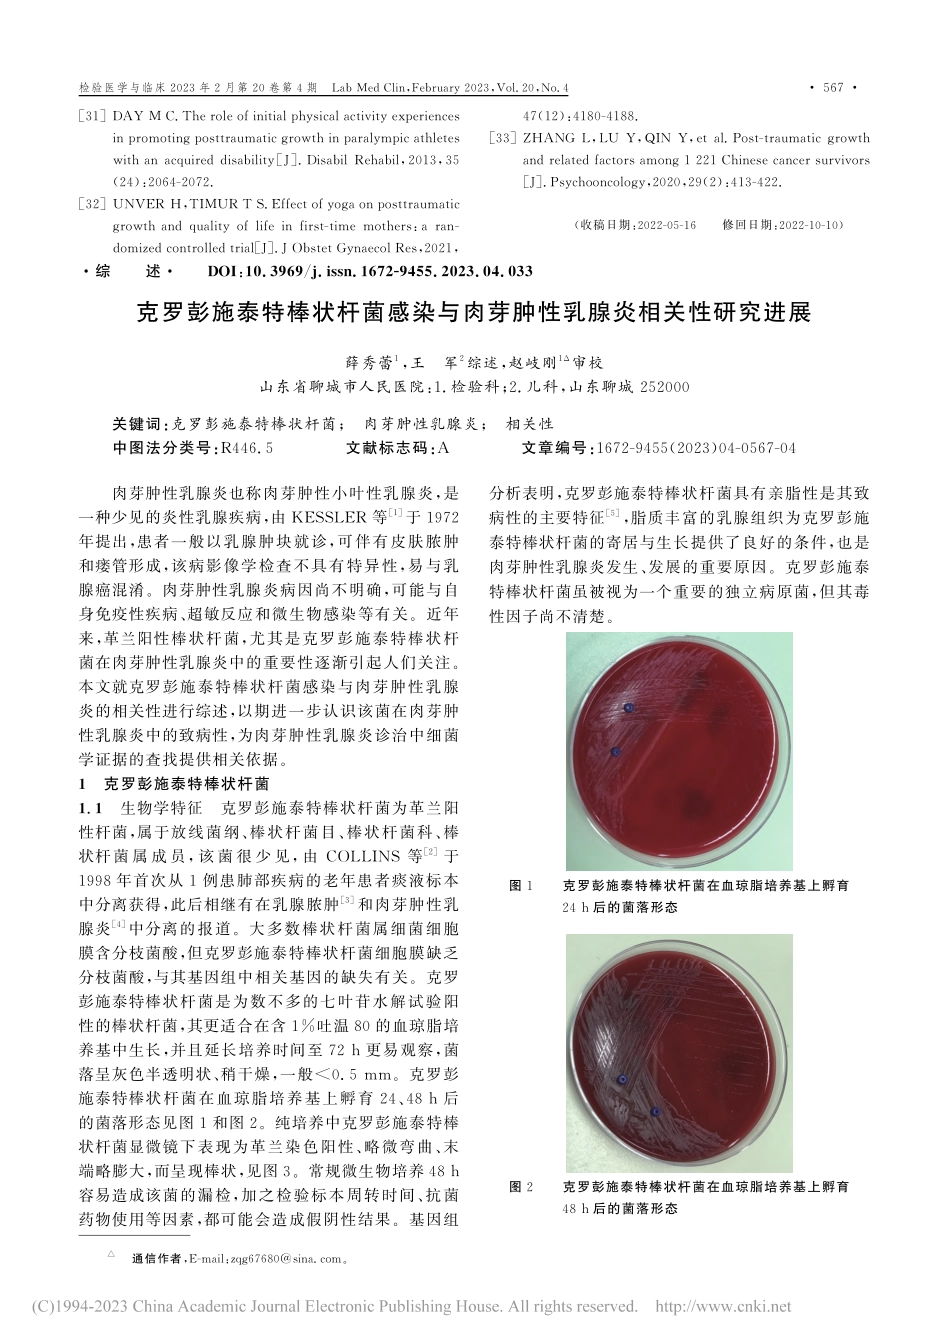
克罗彭施泰特棒状杆菌感染与...芽肿性乳腺炎相关性研究进展_薛秀蕾.pdf_第1页

[31]DAYMC.Theroleofinitialphysicalactivityexperiencesinpromotingposttraumaticgrowthinparalympicathleteswithanacquireddisability[J].DisabilRehabil,2013,35(24):2064-2072.[32]UNVERH,TIMURTS.Effectofyogaonposttraumaticgrowthandqualityoflifeinfirst-timemothers:aran-domizedcontrolledtrial[J].JObstetGynaecolRes,2021,47(12):4180-4188.[33]ZHANGL,LUY,QINY,etal.Post-traumaticgrowthandrelatedfactorsamong1221Chinesecancersurvivors[J].Psychooncology,2020,29(2):413-422.(收稿日期:2022-05-16修回日期:2022-10-10)△通信作者,E-mail:zqg67680@sina.com。·综述·DOI:10.3969/j.issn.1672-9455.2023.04.033克罗彭施泰特棒状杆菌感染与肉芽肿性乳腺炎相关性研究进展薛秀蕾1,王军2综述,赵岐刚1Δ审校山东省聊城市人民医院:1.检验科;2.儿科,山东聊城252000关键词:克罗彭施泰特棒状杆菌;肉芽肿性乳腺炎;相关性中图法分类号:R446.5文献标志码:A文章编号:1672-9455(2023)04-0567-04肉芽肿性乳腺炎也称肉芽肿性小叶性乳腺炎,是一种少见的炎性乳腺疾病,由KESSLER等[1]于1972年提出,患者一般以乳腺肿块就诊,可伴有皮肤脓肿和瘘管形成,该病影像学检查不具有特异性,易与乳腺癌混淆。肉芽肿性乳腺炎病因尚不明确,可能与自身免疫性疾病、超敏反应和微生物感染等有关。近年来,革兰阳性棒状杆菌,尤其是克罗彭施泰特棒状杆菌在肉芽肿性乳腺炎中的重要性逐渐引起人们关注。本文就克罗彭施泰特棒状杆菌感染与肉芽肿性乳腺炎的相关性进行综述,以期进一步认识该菌在肉芽肿性乳腺炎中的致病性,为肉芽肿性乳腺炎诊治中细菌学证据的查找提供相关依据。1克罗彭施泰特棒状杆菌1.1生物学特征克罗彭施泰特棒状杆菌为革兰阳性杆菌,属于放线菌纲、棒状杆菌目、棒状杆菌科、棒状杆菌属成员,该菌很少见,由COLLINS等[2]于1998年首次从1例患肺部疾病的老年患者痰液标本中分离获得,此后相继有在乳腺脓肿[3]和肉芽肿性乳腺炎[4]中分离的报道。大多数棒状杆菌属细菌细胞膜含分枝菌酸,但克罗彭施泰特棒状杆菌细胞膜缺乏分枝菌酸,与其基因组中相关基因的缺失有关。克罗彭施泰特棒状杆菌是为数不多的七叶苷水解试验阳性的棒状杆菌,其更适合在含1%吐温80的血琼脂培养基中生长,并且延长培养时间至72h更易观察,菌落呈灰色半透明状、稍干燥,一般<0.5mm。克罗彭施泰特棒状杆菌在血琼脂培养基上孵育24、48h后的菌落形态见图1和图2。纯培养中克罗彭施泰特棒状杆菌显微镜下表...